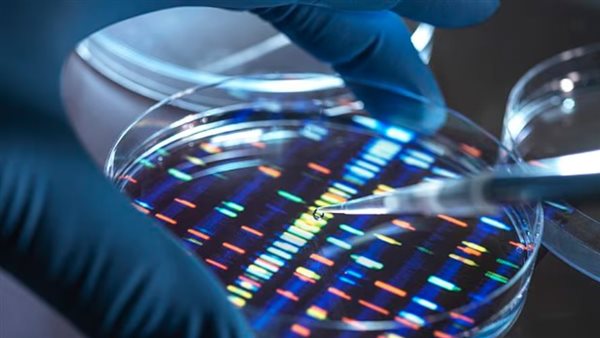
مختبر علمي

هل الحمض النووي الصناعي يجعل الإنسان آمنًا من الأمراض؟.. علماء بريطانيون يثيرون الجدل
أعلن علماء بريطانيون عن تقدم مثير للجدل في مشروع يهدف إلى تصنيع الحمض النووي البشري من الصفر داخل المختبرات، ما أثار مخاوف أخلاقية وتحذيرات من مخاطر محتملة على البشرية.
علماء يثيرون الجدل بتقدمهم في تصنيع الحمض النووي
وحسب ما نشرته صحيفة ديلي ميل البري هدف هذا المشروع الطموح إلى تصميم كروموسومات بشرية اصطناعية، عبر تطوير أدوات متقدمة تتيح بناء سلاسل كبيرة ومعقدة من الحمض النووي وإدخالها في خلايا الجلد البشرية، لدراسة آليات عملها، ويأمل الباحثون أن تُسهم هذه التقنية في تطوير علاجات مبتكرة لأمراض مستعصية مثل اضطرابات المناعة الذاتية، وقصور القلب، والعدوى الفيروسية، وأمراض الشيخوخة.
ورغم الفوائد الطبية المتوقعة، أثار المشروع قلق عدد من العلماء والناشطين في مجال الأخلاقيات العلمية، الذين شبّهوا الأمر بـ اللعب بالنار، وقال الدكتور بيل إيرنشو، من جامعة إدنبرة: لقد خرج المارد من القمقم. إذا أرادت أي جهة تملك المعدات المناسبة تصنيع أي شيء، فلن يكون بمقدورنا إيقافها، أما الناشط في الأخلاقيات الجينية الدكتور بات توماس، فحذّر من أن العلم قد يُعاد توجيهه لأغراض خطيرة، بما في ذلك الاستخدامات العسكرية أو إنتاج أسلحة بيولوجية.
وتشارك في المشروع فرق بحثية من جامعات رائدة مثل أكسفورد، وكامبريدج، ومانشستر، وكينت، إلى جانب إمبريال كوليدج لندن، ويُتوقع أن تمتد أبحاثهم على مدى السنوات الخمس المقبلة، مع التركيز في المرحلة الأولى على فهم أعمق لتأثير الحمض النووي في الصحة البشرية والشيخوخة.
ويتيح بناء الحمض النووي الاصطناعي بدلًا من تعديله كما هو الحال في تقنيات التحرير الجيني للعلماء قدرًا غير مسبوق من التحكم في التجارب، ما يسمح لهم باختبار نظريات بيولوجية جديدة وفهم وظيفة الجينات والمناطق المظلمة من الجينوم، التي لا تُنتج بروتينات ولكن يُعتقد أن لها دورًا مهمًا في تنظيم نشاط الخلايا.
وقال الدكتور جوليان سيل، من مختبر الأحياء الجزيئية التابع لمجلس البحوث الطبية في كامبريدج، إن هذا العمل يسعى إلى تطوير علاجات تساعد البشر على التقدم في السن بصحة أفضل وبتعرض أقل للأمراض، كما أشار إلى إمكانية الاستفادة من التقنية لتطوير أنسجة مقاومة للفيروسات أو لإصلاح الأعضاء المتضررة مثل القلب والكبد.
بدوره، لفت الدكتور ماثيو هيرلز من معهد ويلكوم سانجر، إلى أن القدرة على بناء الحمض النووي من البداية قد تحدث ثورة في الطب، من خلال فهم أفضل لكيفية نشوء الأمراض على المستوى الخلوي وإمكانية معالجتها من جذورها.
وفي حين لا تزال التطبيقات العلاجية الكاملة لهذا المشروع بعيدة المنال، فإن العلماء يتوقعون أن تسفر الأبحاث عن اختراقات هائلة في مجالات زراعة الأعضاء الاصطناعية، والعلاجات الجينية، وتصنيع أنسجة مقاومة للأمراض.
ومع ذلك، لا يغيب عن المشهد الجانب المظلم من هذه التكنولوجيا، فقد حذّر أستاذ الفلسفة إيان براسينجتون من جامعة مانشستر من أن استخدام الحمض النووي الاصطناعي في إنتاج كائنات مُعدّلة مختبريًا مثل البكتيريا القادرة على تنظيف النفط أو تحلل البلاستيك، قد يؤدي إلى نتائج بيئية كارثية إذا أُطلق دون رقابة.
وقال براسينجتون: تسرب مثل هذه الكائنات إلى البيئة قد تكون له تبعات وخيمة لا يمكن التنبؤ بها.






















